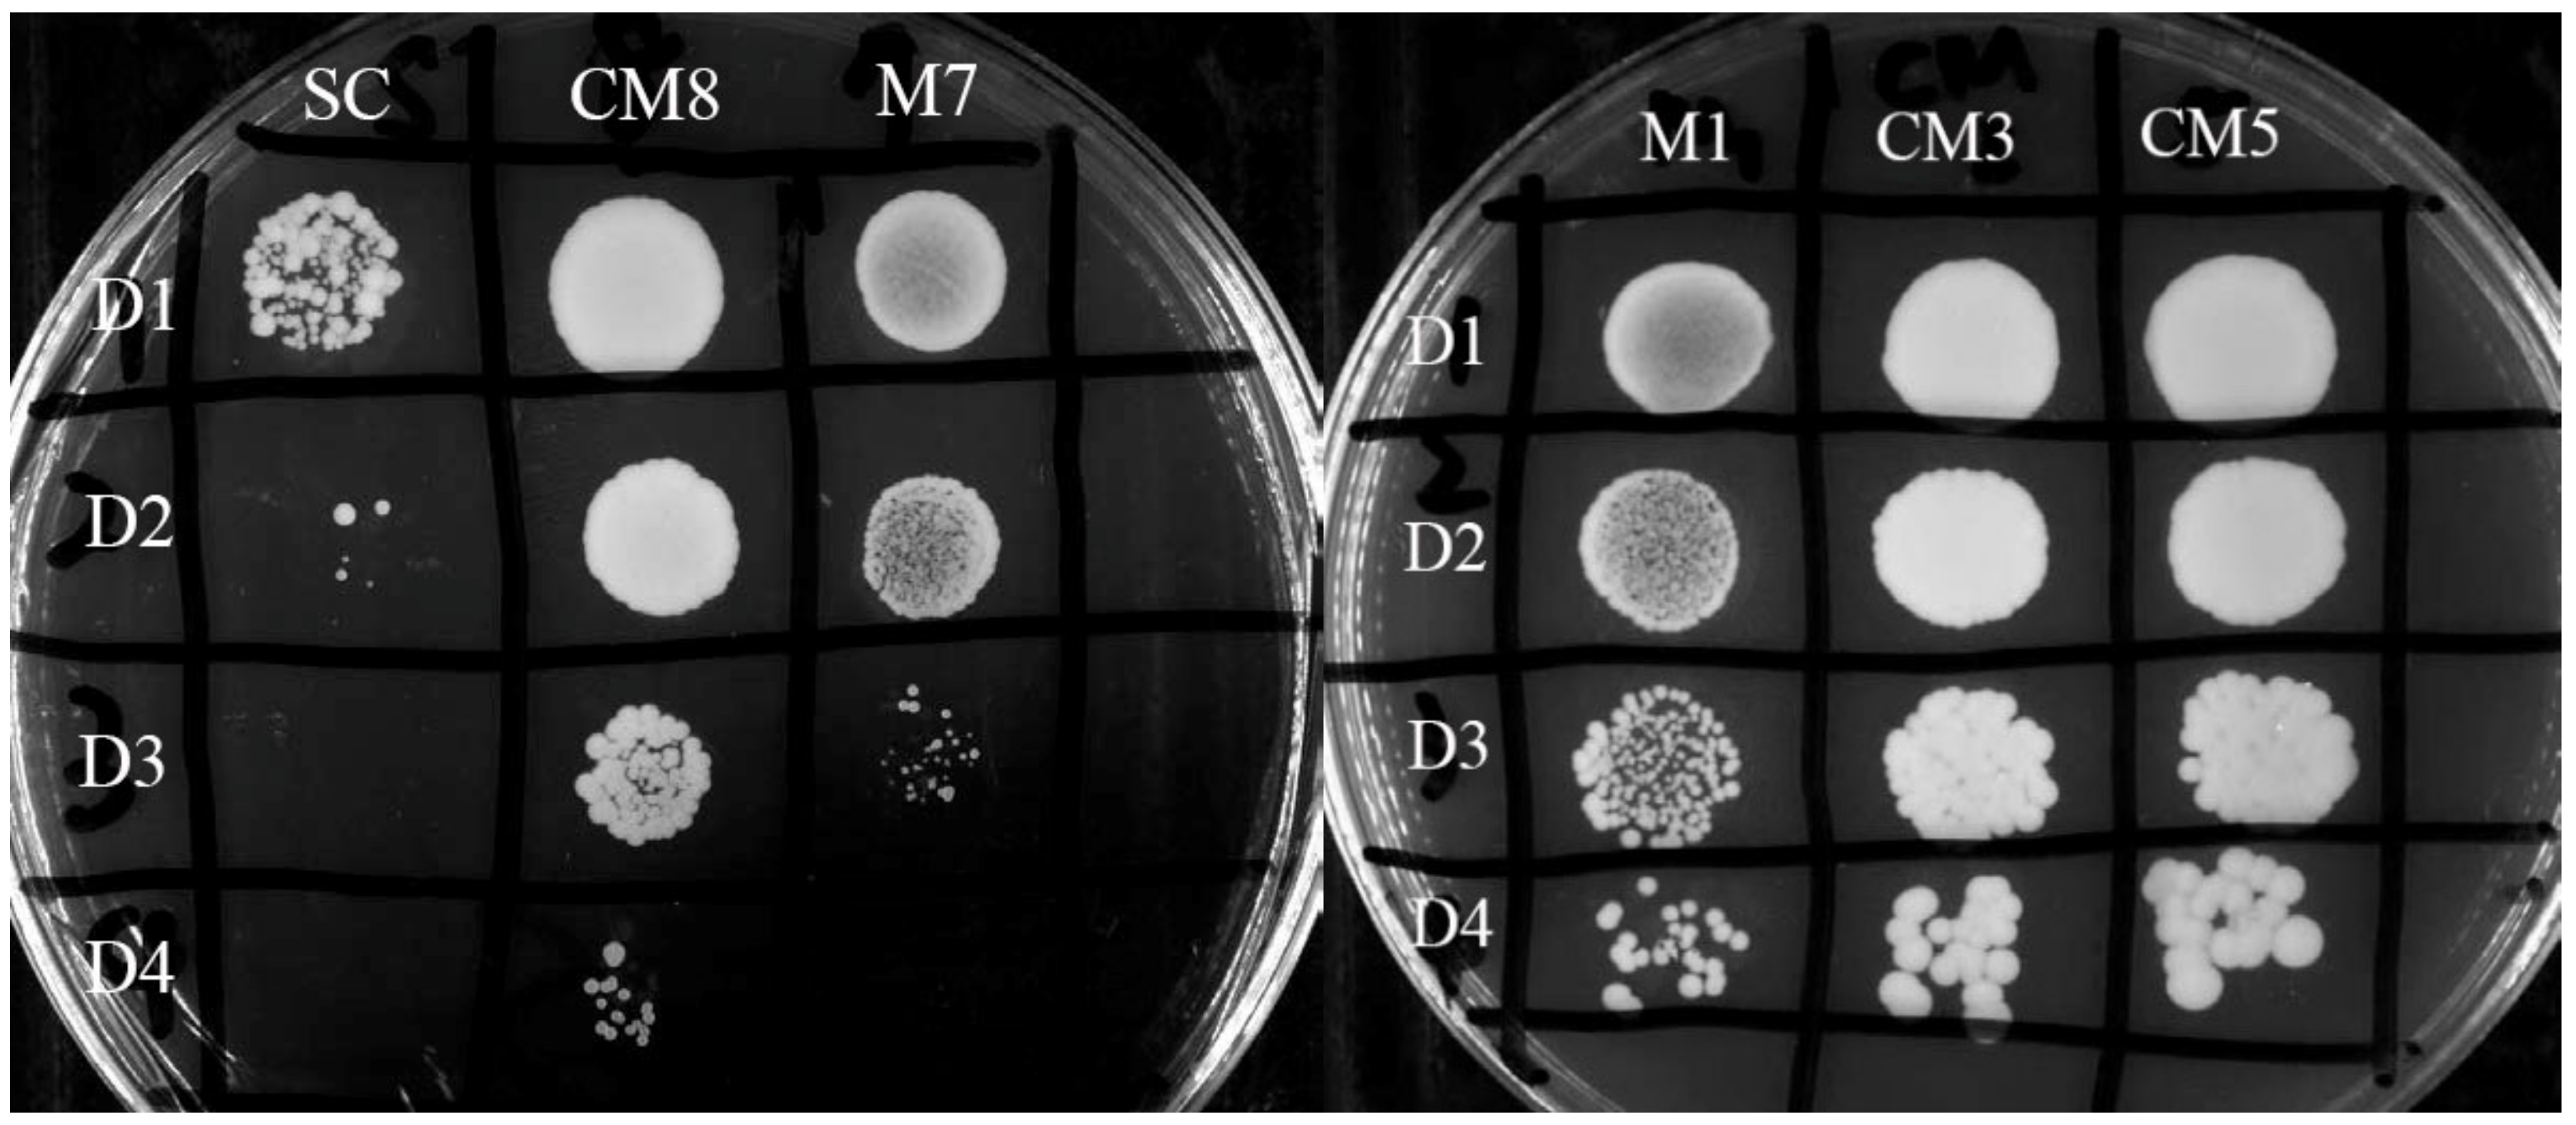
Processes 08 01483 g001

Improved Phenolic Compositions and Sensory Attributes of Red Wines by Saccharomyces cerevisiae Mutant CM8 Overproducing Cell-Wall Mannoproteins
Abstract
1. Introduction
2. Materials and Methods
2.1. Materials and Chemicals
2.2. S. Cerevisiae Mutants with Over-Producibility for Mannoproteins
2.2.1. UV Mutagenesis
2.2.2. Chemical Mutagenesis
2.2.3. Selection of Mannoprotein-Overexpressed Mutants
2.2.4. Analysis of Mannose and Glucose Contents in Cell Walls
2.2.5. Quantification of Mannoproteins in Yeast Mutants
2.3. Production of Red Wine
2.4. Physicochemical Determinations for Red Wines
2.4.1. pH Value
2.4.2. Ethanol Concentration
2.4.3. Titratable Acidity
2.4.4. Total Phenolics, Flavonoids, and Tartaric Ester Contents
2.4.5. Anthocyanins Composition Assay
2.4.6. Total Tannin Content
2.4.7. Chromatic Characteristics
2.5. Sensory Evaluation of Red Wine
| Like extremely: 9 points | Dislike slightly: 4 points |
| Like very much: 8 points | Dislike moderately: 3 points |
| Like moderately: 7 points | Dislike very much: 2 points |
| Like slightly: 6 points | Dislike extremely: 1 point |
| Neither like nor dislike: 5 points |
2.6. Statistical Analysis
3. Results
3.1. Mannoproteins Contents of S. Cerevisiae Mutants
3.2. Quality of Red Wine Fermented by S. Cerevisiae Mutants
3.3. Sensory Properties of Red Wine Fermented by S. Cerevisiae Mutants
3.4. Principal Factors Governing Sensory Preference of Wines
4. Discussion
5. Conclusions
Supplementary Materials
Author Contributions
Funding
Conflicts of Interest
References
- Gorter de Vries, A.R.; Pronk, J.T.; Daran, J.G. Lager-brewing yeasts in the era of modern genetics. FEMS Yeast Res. 2019, 19, 1–17. [Google Scholar] [CrossRef] [PubMed]
- Chalier, P.; Angot, B.; Delteil, D.; Doco, T.; Gunata, Z. Interactions between aroma compounds and whole mannoprotein isolated from Saccharomyces cerevisiae strains. Food Chem. 2007, 100, 22–30. [Google Scholar] [CrossRef]
- Quirós, M.; Morales, P.; Pérez-Través, L.; Barcenilla, J.M.; Gonzalez, R. A new methodology to determine cell wall mannoprotein content and release in wine yeasts. Food Chem. 2011, 125, 760–766. [Google Scholar] [CrossRef]
- Rodrigues, A.; Ricardo-Da-Silva, J.M.; Lucas, C.; Laureano, O. Effect of commercial mannoproteins on wine colour and tannins stability. Food Chem. 2012, 131, 907–914. [Google Scholar] [CrossRef]
- Cliff, M.A.; King, M.C.; Schlosser, J. Anthocyanin, phenolic composition, colour measurement and sensory analysis of BC commercial red wines. Food Res. Int. 2007, 40, 92–100. [Google Scholar] [CrossRef]
- Riou, V.; Vernhet, A.; Doco, T.; Moutounet, M. Aggregation of grape seed tannins in model wine-effect of wine polysaccharides. Food Hydrocoll. 2002, 16, 17–23. [Google Scholar] [CrossRef]
- Rinaldi, A.; Coppola, M.; Moio, L. Aging of Aglianico and Sangiovese wine on mannoproteins: Effect on astringency and color. LWT Food Sci. Technol. 2019, 105, 233–241. [Google Scholar] [CrossRef]
- Guadalupe, Z.; Palacios, A.; Ayestarán, B. Maceration enzymes and mannoproteins: A possible strategy to increase colloidal stability and color extraction in red wines. J. Agric. Food Chem. 2007, 55, 4854–4862. [Google Scholar] [CrossRef]
- Guadalupe, Z.; Ayestarán, B. Effect of commercial mannoprotein addition on polysaccharide, polyphenolic, and color composition in red wines. J. Agric. Food Chem. 2008, 56, 9022–9029. [Google Scholar] [CrossRef]
- Sun, X.; Yan, Z.; Zhu, T.; Zhu, J.; Wang, Y.; Li, B.; Meng, X. Effects on the color, taste, and anthocyanins stability of blueberry wine by different contents of mannoprotein. Food Chem. 2019, 279, 63–69. [Google Scholar] [CrossRef]
- Rodrigues, A.; Ricardo-Da-Silva, J.M.; Lucas, C.; Laureano, O. Influence of fining and tartaric stabilisation procedures on white wine mannoprotein content. South Afr. J. Enol. Vitic. 2012, 33, 88–94. [Google Scholar] [CrossRef][Green Version]
- Dupin, I.V.S.; McKinnon, B.M.; Ryan, C.; Boulay, M.; Markides, A.J.; Jones, G.P.; Williams, P.J.; Waters, E.J. Saccharomyces cerevisiae mannoproteins that protect wine from protein haze: Their release during fermentation and lees contact and a proposal for their mechanism of action. J. Agric. Food Chem. 2000, 48, 3098–3105. [Google Scholar] [CrossRef] [PubMed]
- Gonzalez-Ramos, D.; Cebollero, E.; Gonzalez, R. A recombinant Saccharomyces cerevisiae strain overproducing mannoproteins stabilizes wine against protein haze. Appl. Environ. Microbiol. 2008, 74, 5533–5540. [Google Scholar] [CrossRef] [PubMed]
- Sidari, R.; Postorino, S.; Caparello, A.; Caridi, A. Evolution during wine aging of colour and tannin differences induced by wine starters. Ann. Microbiol. 2007, 57, 197–201. [Google Scholar] [CrossRef]
- Sartor, S.; Toaldo, I.M.; Panceri, C.; Caliari, V.; Luna, A.S.; de Gois, J.S.; Bordignon-Luiz, M.T. Changes in organic acids, polyphenolic and elemental composition of rosé sparkling wines treated with mannoproteins during over-lees aging. Food Res. Int. 2019, 124, 34–42. [Google Scholar] [CrossRef]
- Juega, M.; Carrascosa, A.V.; Martinez-Rodriguez, A.J. Effect of short ageing on lees on the mannoprotein content, aromatic profile, and sensorial character of white wines. J. Food Sci. 2015, 80, 384–388. [Google Scholar] [CrossRef]
- Pérez-Través, L.; Querol, A.; Pérez-Torrado, R. Increased mannoprotein content in wines produced by Saccharomyces kudriavzevii × Saccharomyces cerevisiae hybrids. Int. J. Food Microbiol. 2016, 237, 35–38. [Google Scholar] [CrossRef]
- Juega, M.; Gonzalez-Ramos, D.; Bartolome, B.; Carrascosa, A.V.; Martinez-Rodriguez, A.J. Chemical evaluation of white wines elaborated with a recombinant Saccharomyces cerevisiae strain overproducing mannoproteins. Food Chem. 2014, 147, 84–91. [Google Scholar] [CrossRef]
- Quirós, M.; Gonzalez-Ramos, D.; Tabera, L.; Gonzalez, R. A new methodology to obtain wine yeast strains overproducing mannoproteins. Int. J. Food Microbiol. 2010, 139, 9–14. [Google Scholar] [CrossRef]
- Cohen, R.E.; Ballou, L.; Ballou, C.E. Saccharomyces cerevisiae mannoprotein mutants. Isolation of the mnn5 mutant and comparison with the mnn3 strain. J. Biol. Chem. 1980, 255, 7700–7707. [Google Scholar]
- Hong, Z.; Mann, P.; Brown, N.H.; Tran, L.E.; Shaw, K.J.; Hare, R.S.; Didomenico, B. Cloning and characterization of KNR4, a yeast gene involved in (1,3)-β-glucan synthesis. Mol. Cell. Biol. 1994, 14, 1017–1025. [Google Scholar] [CrossRef] [PubMed][Green Version]
- Dikit, P.; Methacanon, P.; Visessanguan, W.; H-kittikun, A.; Maneerat, S. Characterization of an unexpected bioemulsifier from spent yeast obtained from Thai traditional liquor distillation. Int. J. Biol. Macromol. 2010, 47, 465–470. [Google Scholar] [CrossRef] [PubMed]
- OIV (International Organisation of Vine and Wine). Compendium of International Methods of Analysis of Spirituous Beverages of Vitivinicultural Origin. Available online: http://www.oiv.int/en/technical-standards-and-documents/methods-of-analysis/compendium-of-international-methods-of-analysis-of-spirituous-beverages-of-vitivinicultural-origin (accessed on 20 October 2018).
- Harbertson, J.F.; Parpinello, G.P.; Heymann, H.; Downey, M.O. Impact of exogenous tannin additions on wine chemistry and wine sensory character. Food Chem. 2012, 131, 999–1008. [Google Scholar] [CrossRef]
- Li, J.; Karboune, S. A comparative study for the isolation and characterization of mannoproteins from Saccharomyces cerevisiae yeast cell wall. Int. J. Biol. Macromol. 2018, 119, 654–661. [Google Scholar] [CrossRef] [PubMed]
- Mekoue Nguela, J.; Poncet-Legrand, C.; Sieczkowski, N.; Vernhet, A. Interactions of grape tannins and wine polyphenols with as yeast protein extract, mannoproteins and β-glucan. Food Chem. 2016, 210, 671–682. [Google Scholar] [CrossRef]
- Li, J.; Bindon, K.; Bastian, S.E.P.; Jiranek, V.; Wilkinson, K.L. Use of winemaking supplements to modify the composition and sensory properties of Shiraz wine. J. Agric. Food Chem. 2017, 65, 1353–1364. [Google Scholar] [CrossRef]

| Strain A | Glucose (G) | Mannose (M) | M/G | Mannoproteins |
|---|---|---|---|---|
| (mg/g) | (mg/g) | molar ratio | (mg/g) | |
| SC | 151.0 ± 1.3 a,B | 298.0 ± 15.7 b | 1.97 ± 0.09 b | 340.1 ± 0.6 b |
| M1 | 97.5 ±8.6 c | 231.2 ± 20.3 cd | 2.37 ± 0.00 b | − C |
| M7 | 104.2 ±2.1 bc | 215.2 ± 6.5 d | 2.06 ±0.02 b | − |
| CM3 | 126.1 ± 2.7 b | 267.0 ± 6.7 bc | 2.12 ±0.10 b | − |
| CM5 | 123.5 ± 11.6 b | 278.5 ± 28.3 b | 2.26 ±0.01 b | − |
| CM8 | 111.9 ± 10.2 b | 477.6 ± 12.5 a | 4.27±0.26 a | 386.8 ± 0.3 a |
| Parameter | Unit B | SC-WIN | SC-SUM | CM8-WIN | CM8-SUM |
|---|---|---|---|---|---|
| pH | 3.94 | 3.93 | 3.94 | 3.94 | |
| Alcohol | (% vol) | 11.90 ± 0.0 b,C | 12.00 ± 0.0 b | 12.56 ± 0.0 a | 12.52 ± 0.0 a |
| Titratable acidity | (g TAE/L) | 1.23 ± 0.04 a | 1.18 ± 0.04 a | 1.01 ± 0.00 b | 1.09 ± 0.04 b |
| Total phenolics (TPC) | (mg GAE/L) | 1409 ± 1 a | 1034 ± 62 b | 1439 ± 37 a | 962 ± 21 c |
| Tartaric esters (TEC) | (mg CAE/L) | 784 ± 18 a | 558 ± 40 b | 774 ± 21 a | 517 ± 7 c |
| Total flavonols (TFC) | (mg QE/L) | 255 ± 52 ab | 206 ± 1 b | 283 ± 4 a | 205 ± 6 b |
| Anthocyanins (ACM3G) | (mg M3G/L) | 11.17 ± 0.03 a | 5.21 ± 0.30 b | 11.01 ± 0.06 a | 5.63 ± 0.23 b |
| Total anthocyanins | Aace | 1.436 ± 0.002 b | 0.659 ± 0.001 d | 1.484 ± 0.003 a | 0.677 ± 0.002 c |
| Co-pigmented | % | 2.0 ± 0.2 c | 2.9 ± 0.2 ab | 3.1±0.0 a | 0.8 ± 0.1 d |
| Monomeric | % | 37.4 ± 0.3 a | 35.5 ± 0.5 c | 35.9 ± 0.1 c | 36.7 ± 0.2 b |
| Polymeric | % | 60.6 ± 0.1 d | 61.6 ± 0.3 b | 61.0 ± 0.0 c | 62.5 ± 0.1 a |
| Total tannins (TTC) | (mg CE/L) | 310.0 ± 8.8 b | 244.4 ± 11.5 d | 405.0 ± 1.8 a | 274.4 ± 6.2 c |
| L * | 55.50 ± 0.01 c | 76.85 ± 0.07 a | 54.07 ± 0.00 d | 76.28 ± 0.00 b | |
| a * | 38.48 ± 0.00 b | 19.60 ± 0.01 d | 39.12 ± 0.01 a | 19.75 ± 0.00 c | |
| b * | 13.02 ± 0.01 b | 9.43 ± 0.00 d | 13.52 ± 0.00 a | 9.66v0.01 c | |
| Color density | 2.269 ± 0.004 b | 1.139 ± 0.000 d | 2.321 ± 0.006 a | 1.174 ± 0.001 c | |
| Color hue | 1.091 ± 0.001 c | 1.320 ± 0.007 a | 1.100 ± 0.002 c | 1.295 ± 0.006 b | |
| ΔEWIN−SUM D | 28.73 | 29.72 |
| Parameter | SC-WIN | SC-SUM | CM8-WIN | CM8-SUM |
|---|---|---|---|---|
| Color | 6.45 ± 1.45 a,B | 5.10 ± 1.45 b | 6.30 ± 1.46 a | 5.04 ± 1.38 b |
| Flavor | 5.14 ± 1.65 b | 5.16 ± 1.63 b | 5.93 ± 1.84 a | 6.00 ± 1.76 a |
| Aroma | 5.56 ± 1.32 a | 5.53 ± 1.50 a | 5.67 ± 1.36 a | 5.25 ± 1.44 a |
| Overall preference | 5.27 ± 1.60 a | 5.12 ± 1.54 a | 5.51 ± 1.66 a | 5.08 ± 1.63 a |
| AIC | 62 | 58 | 65 | 59 |
| Sum of ranks D | 177 (2.43 ab) | 201 (2.75 b) | 159 (2.18 a) | 194 (2.65 ab) |
| Degree of sweetness | 2.32 ± 1.01 a | 2.10 ± 1.16 a | 2.34 ± 1.25 a | 2.43 ± 1.03 a |
| Degree of acidity | 3.33 ± 1.53 a | 3.14 ± 1.31 a | 3.33 ± 1.25 a | 3.30 ± 1.48 a |
| Degree of astringency | 3.16 ± 1.32 a | 3.11 ± 1.24 a | 3.14 ± 1.02 a | 2.86 ± 1.26 a |
| Variable | Function | R2 C |
|---|---|---|
| Total tartaric esters content (TEC) | 0.565 × TPC − 25.65 A | 0.994 |
| Total flavonols content (TFC) | 0.149 × TPC + 56.7 A | 0.927 |
| Anthocyanins content (ACM3G) | 0.0130 × TPC − 7.48 A | 0.966 |
| Total tannins content (TTC) | 0.229 × TPC + 31.16 A | 0.662 |
| L * | −50.3 × TPC + 127 B | 0.981 |
| a * | 44.2 × TPC − 24.3 B | 0.984 |
| b * | 8.60 × TPC + 0.998 B | 0.972 |
| Color density | 2.63 × TPC − 1.45 B | 0.980 |
| Color hue | −0.484 × TPC + 1.79 B | 0.954 |
| Sensory color score | 3.01 × TPC + 2.07 B | 0.976 |
Publisher’s Note: MDPI stays neutral with regard to jurisdictional claims in published maps and institutional affiliations. |
© 2020 by the authors. Licensee MDPI, Basel, Switzerland. This article is an open access article distributed under the terms and conditions of the Creative Commons Attribution (CC BY) license (http://creativecommons.org/licenses/by/4.0/).
Share and Cite
Lai, P.F.-H.; Hsu, P.-C.; Liou, B.-K.; Divate, R.D.; Wang, P.-M.; Chung, Y.-C. Improved Phenolic Compositions and Sensory Attributes of Red Wines by Saccharomyces cerevisiae Mutant CM8 Overproducing Cell-Wall Mannoproteins. Processes 2020, 8, 1483. https://doi.org/10.3390/pr8111483
Lai PF-H, Hsu P-C, Liou B-K, Divate RD, Wang P-M, Chung Y-C. Improved Phenolic Compositions and Sensory Attributes of Red Wines by Saccharomyces cerevisiae Mutant CM8 Overproducing Cell-Wall Mannoproteins. Processes. 2020; 8(11):1483. https://doi.org/10.3390/pr8111483
Chicago/Turabian StyleLai, Phoency F.-H., Po-Chun Hsu, Bo-Kang Liou, Rupesh D. Divate, Pei-Ming Wang, and Yun-Chin Chung. 2020. "Improved Phenolic Compositions and Sensory Attributes of Red Wines by Saccharomyces cerevisiae Mutant CM8 Overproducing Cell-Wall Mannoproteins" Processes 8, no. 11: 1483. https://doi.org/10.3390/pr8111483
APA StyleLai, P. F.-H., Hsu, P.-C., Liou, B.-K., Divate, R. D., Wang, P.-M., & Chung, Y.-C. (2020). Improved Phenolic Compositions and Sensory Attributes of Red Wines by Saccharomyces cerevisiae Mutant CM8 Overproducing Cell-Wall Mannoproteins. Processes, 8(11), 1483. https://doi.org/10.3390/pr8111483

